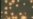
16x9 Image

今年农历春节假期,大陆观光客到台湾旅游的人数创下历年新高。与此同时,开放大陆观光客到台湾做健康检查的措施也已经生效。
今晚的海峡论谈除了比较轻松的跟大家聊一聊,大陆观光客在农历春节期间,组团到台湾吃年夜饭,看元宵灯会。
这些非常特别、有趣的现象之外呢,也要严肃的来探讨,开放大陆观光客到台湾医院健检,除了带来商机,是否也可能会带来一些后遗症,像是最近在香港,一些大陆观光客的特定行为、和所谓的“双非孕妇”到香港产子被称为“蝗虫”。
就在港、陆之间引发很大的争议,台湾和大陆之间,是否也会因为旅游的交流越来越密切而爆发潜在的危机呢?
海峡论谈邀请美国乔治华盛顿大学旅游系主任于良教授,以及台湾师范大学政治研究所的范世平教授来讨论这个话题。